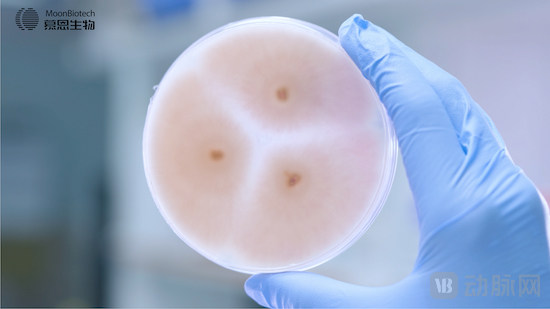
3.jpg

动脉网第一时间获悉,近日,慕恩(广州)生物科技有限公司(以下简称:慕恩生物)完成2亿元C轮融资,由国投创业领投,国投创业陈筑熙博士加入慕恩生物董事会。这是慕恩生物继2021年6月完成过亿元B+轮融资后,年内再次完成亿元级别的融资,持续获得一线资本的青睐。本轮融资将用于继续推进微生物组产业化,强化公司微生物组技术平台的优势,并全面加速两个创新性活菌药物的临床试验及多个农业微生物产品的市场开发和销售。
慕恩生物成立于2015年,是一家国际领先的微生物组平台型技术公司,已搭建起了从发现微生物、筛选微生物、改造微生物到应用微生物的完整微生物组产业化技术体系。公司已建立了全球最大、生物多样性最高的肠道微生物、植物微生物菌种库和基因库,发现、保存和鉴定了超15万株具有自主知识产权的微生物菌株。通过独有的Culture-To-Product技术平台,慕恩生物可高效地持续开发创新的、天然来源的高活性微生物及其代谢产物。


在生物医药板块,慕恩生物依托领先的全谱活菌药物开发平台,瞄准微生物疗法在肿瘤免疫和代谢疾病领域的治疗潜力,正在打造包含9个重磅活菌药物的研发管线,旗下的肿瘤免疫管线MNC-168和代谢疾病管线MNO-863,将在中美两国申报IND。公司先后建立了跟诺和诺德、恒瑞医药、默克中国创新中心等国内外医药巨头的合作,与湖南大学生命医学交叉研究院共建了“工程菌药物联合实验室”,并跟广东省人民医院、解放军301医院等医疗机构达成临床合作。2021年年初,慕恩生物与学术机构合作的科研项目还获得了教育部科技进步一等奖。目前,抗肿瘤活菌药物MNC-168已与恒瑞医药旗下的的阿得贝利单抗(抗PD-L1单抗)展开联合用药的全球临床研究。

在生物农业板块,慕恩商业化路径清晰,瞄准600亿未被满足的生物防治和土壤健康市场,已获得产品证书及在注册的生物农业产品达十余项,公司已推出一系列极具创新性的农业微生物菌剂产品,产品销售额连续3年实现了三倍增长。日前,公司在农业业务已与先正达集团、诺普信、浙江新农、百果园等农业领军企业建立密切的战略合作。慕恩生物2021年与先正达集团共建了“微生物农药联合实验室”,并与其种子业务达成协议合作发掘新一代生物技术性状,共同推动种业“芯片”的创新变革。

慕恩生物创始人&CEO蒋先芝博士表示:非常感谢国投创业的支持和信任,在新老股东的支持下,慕恩生物将继续夯实自身技术和产业优势,包括增强微生物多组学、合成生物学和单菌基因组数据发掘和预测能力,加速活菌药物的临床进展,拓展生物农业产品的市场渠道网络。2022年,慕恩生物一定会在技术创新和产业化方面实现更大突破。
国投创业董事总经理金涛博士表示:慕恩生物在微生物组领域拥有领先的研发能力、创新能力和丰富的产业经验,其活菌药物研发管线在肿瘤免疫、代谢疾病上取得迅速进展,具有极大潜力,同时农业板块产品填补国内空白,得到了业内多家头部企业的合作认可,有望成为中国微生物农用菌剂龙头。我们持续看好并寄予厚望,期待慕恩团队在微生物组领域行稳致远,持续创造价值。
国投创业成立于2016年,是国家开发投资集团为落实国家创新驱动发展战略,深化与科技部全面战略合作,加快推动国家科技成果转移转化,按照市场化方式专门设立的私募股权投资基金管理公司。
国投创业通过国家科技重大专项成果转化基金、国投(广东)科技成果转化创业投资基金、国投京津冀科技成果转化基金、国投高新(深圳)创投基金和国投(宁波)科技成果转化基金等平台,始终围绕科技成果转化投资目标,聚焦先进制造、电子信息、材料能源、生物医药等关键领域,着眼京津冀、长三角、粤港澳大湾区等国家区域发展战略布局,持续推动关键核心技术自主创新不断实现突破,构建良好的科技成果转化投资生态体系。

















